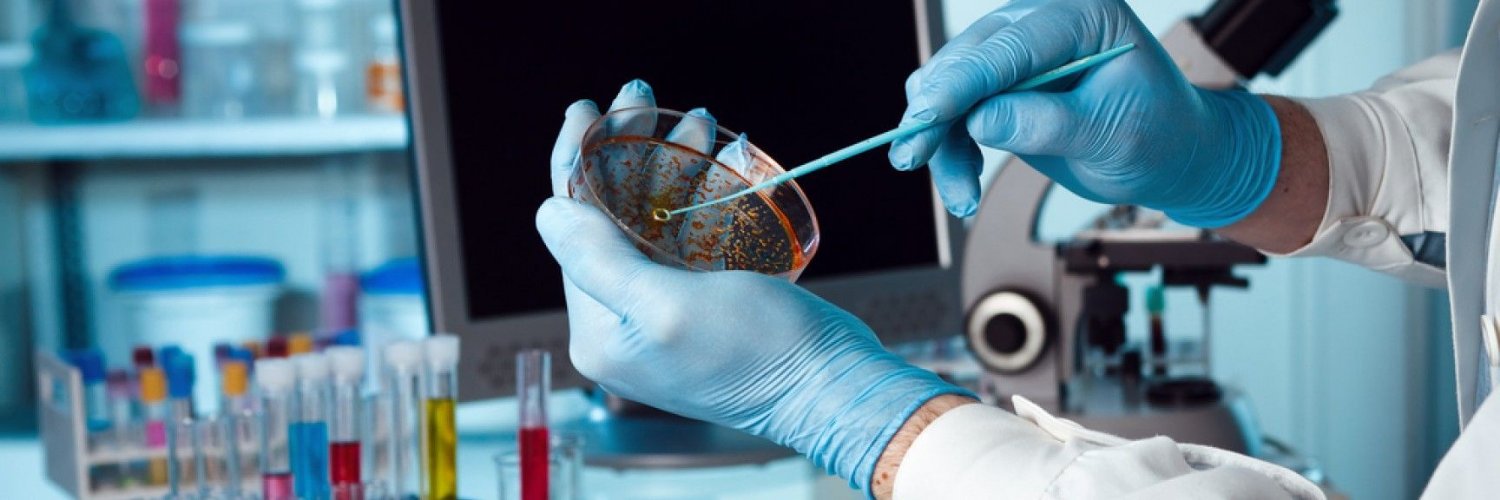
mAbTree Biologics banner

mAbTree Biologics India is headquartered at MNiHub, Genome Valley, Shamirpet, Hyderabad. #mabtreebiologics #mabtree
English
mAbTree Biologics
1 posts

@mabtree
mAbTree Biologics is a start up venture focused on the research, development and production of biosimilars - mAbs & recombinant protein therapeutics.
